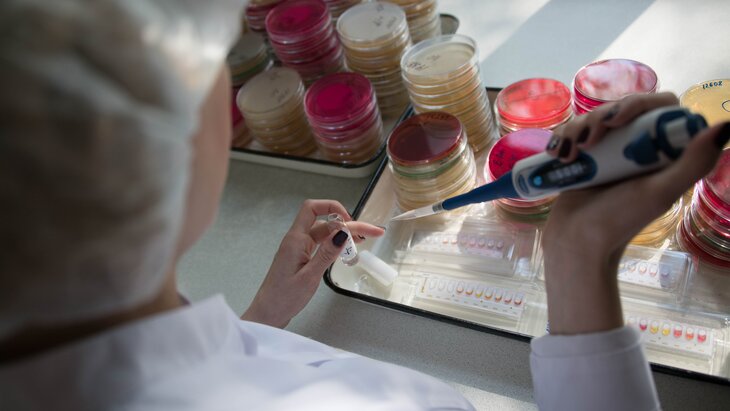

25 декабря 2019, 12:38
НаукаУченые выяснили, когда начинается старение организма
Фото: портал мэра и правительства Москвы/Евгений Самарин
Старение организма начинается сразу после образования самого организма – в момент зачатия. К такому выводу пришли сотрудники Научно-исследовательского института физико-химической биологии имени Белозерского МГУ имени Ломоносова совместно с коллегами из Гарвардского университета. Об этом сообщает Агентство "Москва" со ссылкой на пресс-службу МГУ.
"Анализ эпигенетических меток ДНК, коррелирующих с биологическим возрастом, а также данных о накоплении мутаций позволяет говорить о том, что старение в этом смысле начинается сразу после образования организма – то есть, по сути, в момент зачатия или вскоре после него", – приводятся в сообщении слова одного из авторов статьи по результатам исследования Эльвиры Кинзиной.
Руководитель исследования, профессор МГУ Вадим Гладышев рассказал, что старением являются различные повреждения, которые накапливаются в организме. По его словам, из-за этого постепенно наблюдается утрата функций отдельных клеток, тканей, органов и систем.
Ранее американские ученые из Стэнфордского университета выяснили, что старение человека проходит в несколько этапов. Специалисты проанализировали белки плазмы крови более 4 тысяч добровольцев в возрасте от 18 до 95 лет. Они обнаружили нелинейные изменения в их структуре в зависимости от возраста испытуемых.
В связи с этим исследователи выделили три этапа старения человека. Первый этап наступает в 34 года, второй – в 60 лет, третий – в 78. Такое деление объясняется сдвигами в белках жидкой части крови, которые происходят в организме человека в определенном возрасте.








Собянин: "школу будущего" на 1,1 тыс учеников построят в Пресненском районе























